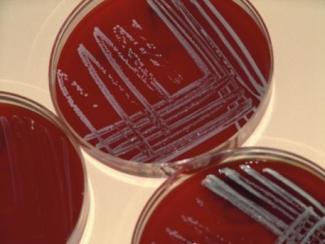

Bakterienkulturen
Bakterien sind sehr klein. Man kann sie nur mit mikroskopischer Vergrößerung beobachten. Aus einem Bakterium entsteht aufgrund seiner schnellen Vermehrung in kurzer Zeit eine große Anzahl von Bakterien. Bleiben diese als lockerer Zellverband dicht zusammen, so sind sie als Bakterienkolonie für das Auge sichtbar. Diese Tatsache nutzt man in der Wissenschaft zur Herstellung einer Bakterienkultur.
Eine Bakterienkolonie wird künstlich aus möglichst einer Bakterie angezüchtet. Bakterienkulturen eignen sich zur Bestimmung der Bakterienart und zur Untersuchung von Bau und Lebensweisen bestimmter Bakterien.
-
emeraldphoto - Fotolia.com
Die Fortpflanzung und Vermehrung der Bakterien erfolgt ungeschlechtlich durch Querteilung. Haben die aus der Teilung entstandenen Bakterien wieder die Größe des Ausgangsbakteriums erreicht, teilen sie sich erneut. Diese Form der ungeschlechtlichen Fortpflanzung wird auch Spaltung genannt. Bei günstigen Lebensbedingungen (u. a. genügend Nahrung, Feuchtigkeit und Temperaturen zwischen +10 °C bis +30 °C) kann sich ein Bakterium alle 20 Minuten teilen. Dadurch können in einem Milliliter Milch nach 24 Stunden bereits 5 Millionen Bakterien vorhanden sein. Nach der Zellteilung können die Bakterien miteinander verbunden bleiben und können so Zellhaufen, einfache und verzweigte Zellketten bilden. Diese Bakterienkolonien haben je nach Bakterium typische Formen und Farben.
Damit sich Bakterien schnell kultivieren lassen, benutzt man geeignete Nährmedien, die die Ernährungsbedingungen optimal widerspiegeln. Die meisten Bakterien benötigen organische Stoffe (z. B. Zucker, Fette, Alkohol). Sie zersetzen diese Stoffe, nehmen Teile davon auf und bauen ihre eigenen organischen Körperstoffe auf. Sie leben heterotroph.
Die Nährmedien unterscheiden sich nach ihrer Konsistenz (feste Nährböden oder flüssige Nährbouillon), nach ihrer Herkunft (natürlich oder synthetisch) und nach ihrer Verwendbarkeit (allgemein oder speziell). Durch eine geeignete Variation der Zusatzstoffe in einem Nährmedium lässt dieses sich je nach Bakterienart und Untersuchungsziel an vielfältige Bedürfnisse anpassen. Soll eine Bakterienkultur zum Beispiel auf spezifische Resistenzen untersucht werden, wird ein Antibiotikum hinzugegeben. Dann handelt es sich um ein spezielles oder auch Selektivmedium.
Für die medizinische Diagnostik werden meist runde Schälchen mit einem festen Nährboden aus Agar benutzt. Um herauszufinden, um welches Bakterium es sich bei einer bestimmten Krankheit handelt, werden Proben aus der Infektionsstelle oder aus Blut, Sputum, Auswurf oder Urin entnommen und auf die Nährbodenoberfläche hauchdünn aufgetragen (Ausstrich). Dadurch will man erreichen, dass die Bakterien vereinzelt auf dem Nährboden liegen. Aus jedem einzelnen Bakterium entsteht dann unter idealen Lebensbedingungen (Temperatur, Feuchtigkeit, pH-Wert usw.) in kurzer Zeit eine Bakterienkolonie, die aus den Klonen des einzelnen Bakteriums entstanden ist, eine sogenannte Reinkultur. An der Wachstumsform, ihrer Farbe und mithilfe weiterer Untersuchungen kann man dann die Bakterienart bestimmen und somit die Krankheit.
Neben der medizinischen Diagnostik ist auch die Bestimmung von Bakterien, die Nahrungsmittel verderben, wichtig für den Menschen. Um vorab eine rasche Vermehrung von Bakterien auf Lebensmitteln einzudämmen oder zu verhindern, werden die Lebensbedingungen für sie ungünstig gestaltet, z. B. durch Schaffung niedriger Temperaturen, durch Erhitzen ihrer Nahrungsstoffe auf +105 °C oder durch Wasserentzug (Trocknen und Dörren), Räuchern oder Einsalzen. Dies wird bei der Lagerung von Nahrungsmitteln und Futterstoffen ausgenutzt (z. B. Kühlschränke, Kühlhallen, Lagerhallen für Trockennahrung bzw. Trockenfutter).
Die Vermehrung der Bakterien wird auch durch UV-Strahlung eingeschränkt.
Sind die Lebensbedingungen ungünstig (Nahrung, Feuchtigkeit, Temperatur), können einige stäbchenförmige Bakterien (Bazillen) Dauersporen bilden. Diese Sporen sind sehr widerstandsfähig gegen Trockenheit, Kälte und Hitze sowie auch gegen Chemikalien und UV-Strahlen. In dieser Form können Bakterien Jahre überdauern. Durch Luftbewegung, an der Haut haftend oder durch Verkehrsmittel können sie weltweit verbreitet werden. Gelangen die Sporen in günstige Lebensbedingungen, bricht die feste „Sporenhülle“ auf und aus der Spore entwickelt sich ein neues Bakterium.

